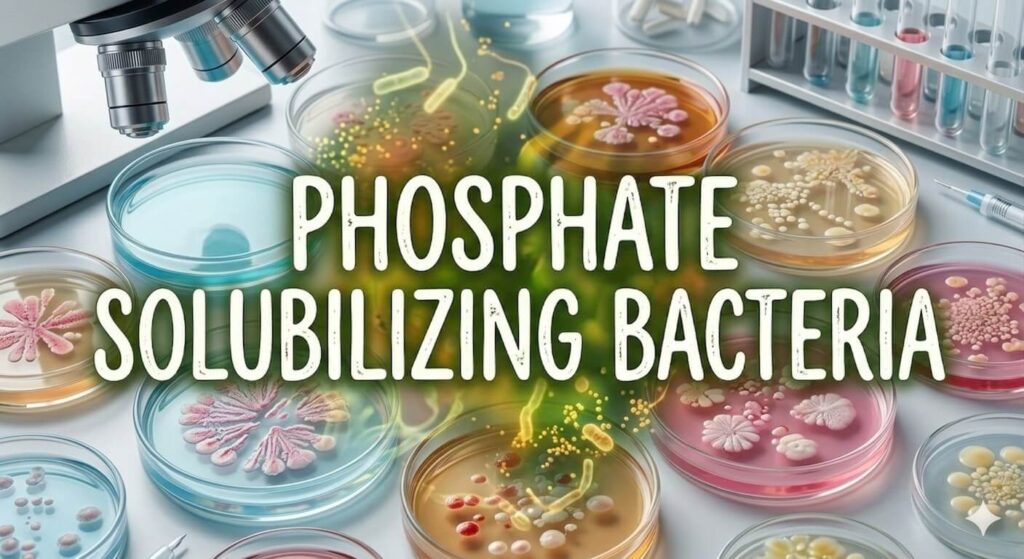
Phosphate Solubilizing Bacteria

Deep under the soil, plant roots move like little explorers. They are always searching for food. One very important food is phosphorus. Plants need phosphorus to grow strong roots, make flowers, and give fruits. But here is the problem: phosphorus in the soil is locked up, like treasure inside a box with a tight lock. Plants can see it, but they cannot use it.
Now imagine a tiny invisible friend living underground. This friend carries a magic key. Its name is PSB – Phosphate Solubilizing Bacteria. PSB works like a treasure unlocker. PSB produces natural organic acids such as gluconic acid, citric acid, oxalic acid, and others. These acids spread into the soil around the phosphorus compounds. These acids help dissolve the hard, insoluble phosphorus compounds present in soil. Among them, gluconic acid is especially powerful. These acids, especially gluconic acid, bind with the metal ions holding phosphorus. It works by loosening the grip of metals like calcium (Ca²⁺), aluminum (Al³⁺), and iron (Fe³⁺) that hold phosphorus tightly. When these metals let go, the phosphate is released into the soil. This process is called chelation.
Once the metals let go, the phosphorus becomes soluble. It changes into phosphate ions that plants can easily absorb through their roots. The plant takes up the released phosphate. The work happens quietly, but the results are big: stronger roots, greener leaves, and healthier crops. For plants, it feels like finding food that was always there but unreachable. For farmers, it means saving money and keeping the soil fertile for many years.
Phosphorus is the second most important nutrient after nitrogen, and without it plants cannot grow properly. It plays a key role in building strong roots, helping flowers to bloom, and making fruits bigger and healthier. When phosphorus is missing, plants look weak, leaves lose their shine, flowers are fewer, and fruits remain small and underdeveloped. In short, the entire energy system of the plant slows down.
PSB makes sure crops get the energy they need. Farmers who use PSB see better yields in wheat, rice, mustard, tomato, potato, and even fruit crops.
Using PSB is simple. It comes in powder or liquid form. Farmers can coat seeds before sowing, mix it with compost and spread it in the field, or dip seedlings in PSB solution before planting. Moist soil with organic matter is best, because the bacteria need food and water to live.
The long‑term gift of PSB is even greater. It keeps phosphorus moving in the soil, supports other good microbes, and reduces the need for chemicals. Farmers who use it regularly find their land stays healthy and productive year after year.
So the story of PSB is the story of a hidden treasure and a loyal friend with a key. Plants cannot open the lock, but PSB does it happily. The farmer sees the reward in stronger crops, better harvests, and fertile soil. Though PSB works quietly underground, its gifts shine in every harvest.